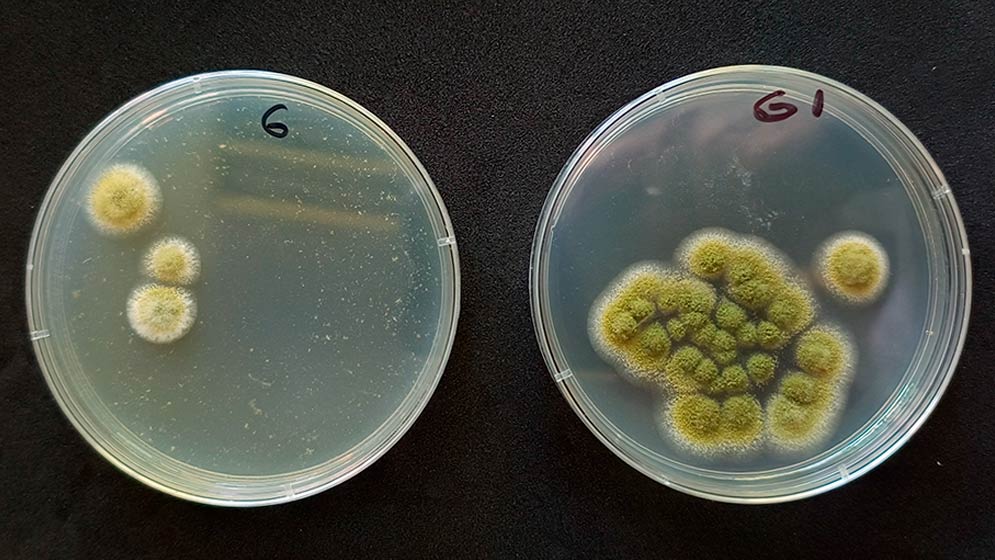

Combaten un hongo en semillas y cereales con el extracto de un árbol que crece en el noroeste argentino
Especialistas de tres instituciones trabajan a la par para desarrollar las propiedades del ibirá pitá. Buscan frenar que se desarrolle en granos durante la etapa poscosecha, convirtiéndose en una amenaza para la salud humana y animal.
El Ibirá pitá puede alcanzar hasta cuarenta metros de altura y que llama la atención por sus flores amarillas.
Un antifúngico formulado a partir de un extracto del árbol Ibirá pitá (Peltophorum dubium: Fabaceae/Leguminosae), posee la capacidad de controlar el crecimiento de hongos de la especie Aspergillus flavus, confirmaron expertos del CONICET, el Instituto Nacional de Tecnología Agropecuaria (INTA) y la Facultad de Farmacia y Bioquímica de la Universidad de Buenos Aires.
Frente a un tipo de hongo que produce micotoxinas y cuya contaminación derivada puede poner en riesgo tanto la salud humana como la animal, en el caso de ser combatido con formulaciones sintéticas se sabe que también tiene la capacidad de generar cierta resistencia por lo que la posibilidad de recurrir a estas alternativas naturales se vuelve aún más valiosa.
Los beneficios de un árbol contra un hongo | Solución natural para evitar contaminación
“Con el tiempo, las formulaciones sintéticas obligan a la administración de dosis más altas, con los potenciales riesgos de contaminación ambiental que esto conlleva. En cambio, los antifúngicos de origen vegetal, están conformados por un conjunto más amplio de compuestos activos (metabolitos secundarios) cuya actividad antifúngica es esperable que se mantenga estable”, valoraron desde el equipo que logró impulsarlo.
Renée H. Fortunato, investigadora del CONICET y directora del Instituto de Botánica Darwinion (IBODA, CONICET-ANCEFEN) es la líder del equipo de trabajo, que logró este nuevo producto natural que permita combatir esta afección de los granos almacenados y que ocasiona, a su vez, importantes pérdidas económicas. “Por eso, actualmente estamos participando de reuniones con diversas empresas del sector agro industrial, interesadas en el desarrollo de este bioinsumo”, comentó.

Los beneficios de un árbol contra un hongo | Donde crece el Ibirá pitá
“En estos momentos estamos en la etapa de desarrollo de un prototipo de bioinsumo y tenemos puesto a punto un bioensayo para probarlo sobre la superficie de los granos de maíz, que serían el nicho de este desarrollo. Luego, hay que poder escalarlo de modo que pueda ser aplicado en los granos antes del ingreso al silo”, señaló Lucía Di Ciaccio, investigadora del INTA en el Instituto de Patobiología Veterinaria (IPVET, CONICET-INTA), y una de las responsables del desarrollo.
El Ibirá pitá, un árbol que puede alcanzar hasta cuarenta metros de altura y que llama la atención por sus flores amarillas, crece naturalmente en el Chaco Oriental y en las selvas altas de Misiones, Corrientes, Formosa, llegando a extender su presencia hasta el norte de Santa Fe. «Su interés ornamental ha permitido su cultivo en el arbolado urbano de Buenos Aires y otras ciudades del país», concluyeron.
Un antifúngico formulado a partir de un extracto del árbol Ibirá pitá (Peltophorum dubium: Fabaceae/Leguminosae), posee la capacidad de controlar el crecimiento de hongos de la especie Aspergillus flavus, confirmaron expertos del CONICET, el Instituto Nacional de Tecnología Agropecuaria (INTA) y la Facultad de Farmacia y Bioquímica de la Universidad de Buenos Aires.
Registrate gratis
Disfrutá de nuestros contenidos y entretenimiento
Suscribite por $1500 ¿Ya estás suscripto? Ingresá ahora